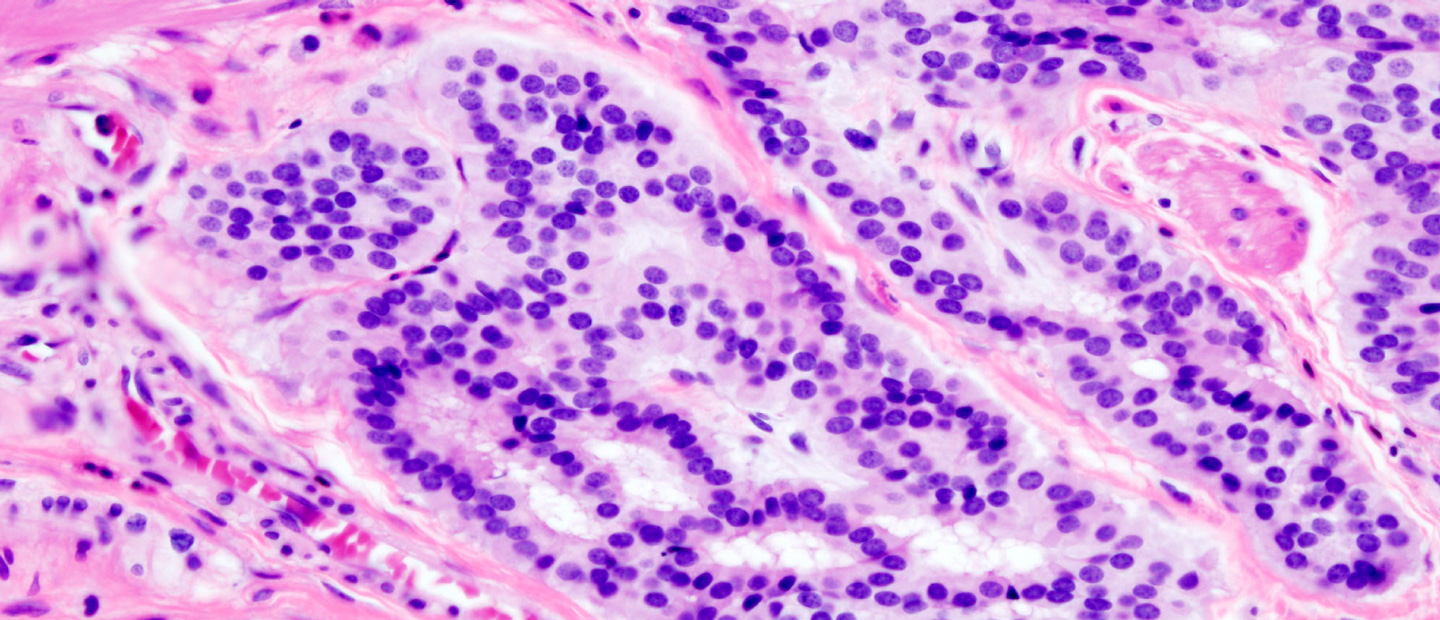

- 6 de julio de 2020
Diferencias entre los rayos UVA y UVB
- 3 de julio de 2020
¿Por qué es importante el uso del protector solar?
- 2 de julio de 2020
¿Qué debo hacer al salir y llegar de nuevo al hogar?
- 26 de junio de 2020
Uso responsable de los dispositivos móviles en niños y adolescentes
- 21 de junio de 2020
El Cáncer de Próstata, la sana prevención es clave en su tratamiento
- 17 de junio de 2020
Disfunción eréctil
- 13 de junio de 2020
Por una fertilidad sana
- 12 de junio de 2020
¿Por qué la fibra previene algún tipo de cáncer, cómo el de colon?
- 7 de junio de 2020
Estreñimiento en niños
- 23 de mayo de 2020
Reemplazo de cadera y su etapa de recuperación
- 16 de mayo de 2020
Crianza en tiempos de estrés
- 28 de abril de 2020
Diferencias entre el Coronavirus, Influenza y Dengue
- 28 de abril de 2020
Insomnio en tiempos de COVID
- 28 de abril de 2020
Principales recomendaciones que deben tener los pacientes mayores de 70 años
- 26 de abril de 2020
Medicación responsable en tiempos de CORONAVIRUS
- 17 de abril de 2020
Hemofilia: Una condición de vida costosa.